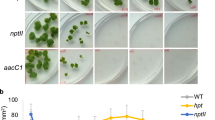

Abstract
INJECTION of homogenates of active prothoracic glands into fourth instar locust larvæ, a day after moulting, causes them to moult again prematurely. The instar is shortened by about 12–18 h (Fig. 1). The active agent appears to be an ecdysone (which we have named ecdysone-λ). Injection of those fractions of extracts of whole locusts that contain ecdysone-λ have a similar effect. The plant growth hormone gibberellic acid likewise shortens the instar when injected at the appropriate time into larvse of both Locusta migratoria migratorioides (R. and F.) and Schistocerca gregaria (Forskäl) (Fig. 1).
This is a preview of subscription content, access via your institution
Access options
Subscribe to this journal
Receive 51 print issues and online access
$199.00 per year
only $3.90 per issue
Buy this article
- Purchase on SpringerLink
- Instant access to full article PDF
Prices may be subject to local taxes which are calculated during checkout
Similar content being viewed by others
References
Haskell, P. T., and Moorhouse, J. E., Nature, 197, 56 (1963).
Brian, P. W., and Hemming, H. G., Physiol. Plant., 8, 669 (1955).
Author information
Authors and Affiliations
Rights and permissions
About this article
Cite this article
CARLISLE, D., OSBORNE, D., ELLIS, P. et al. Reciprocal Effects of Insect and Plant-growth Substances. Nature 200, 1230 (1963). https://doi.org/10.1038/2001230a0
Issue date:
DOI: https://doi.org/10.1038/2001230a0
This article is cited by
-
10.1007/BF00338451
CrossRef Listing of Deleted DOIs (2011)
-
Phytoecdysteroids and Other Biologically Active Compounds from Plants of the Genus Ajuga
Chemistry of Natural Compounds (2005)
-
Phytoecdysteroids of plants of the genusAjuga and their biological activity 1. Distribution and chemical structures of the compounds isolated
Chemistry of Natural Compounds (1994)
-
Regulation of grasshopper fecundity, longevity and egg viability by plant growth hormones
Experientia (1980)
-
The role of phytoecdysteroids in bracken fern,Pteridium aquilinum (L.) Kuhn as a defense against phytophagous insect attack
Journal of Chemical Ecology (1978)